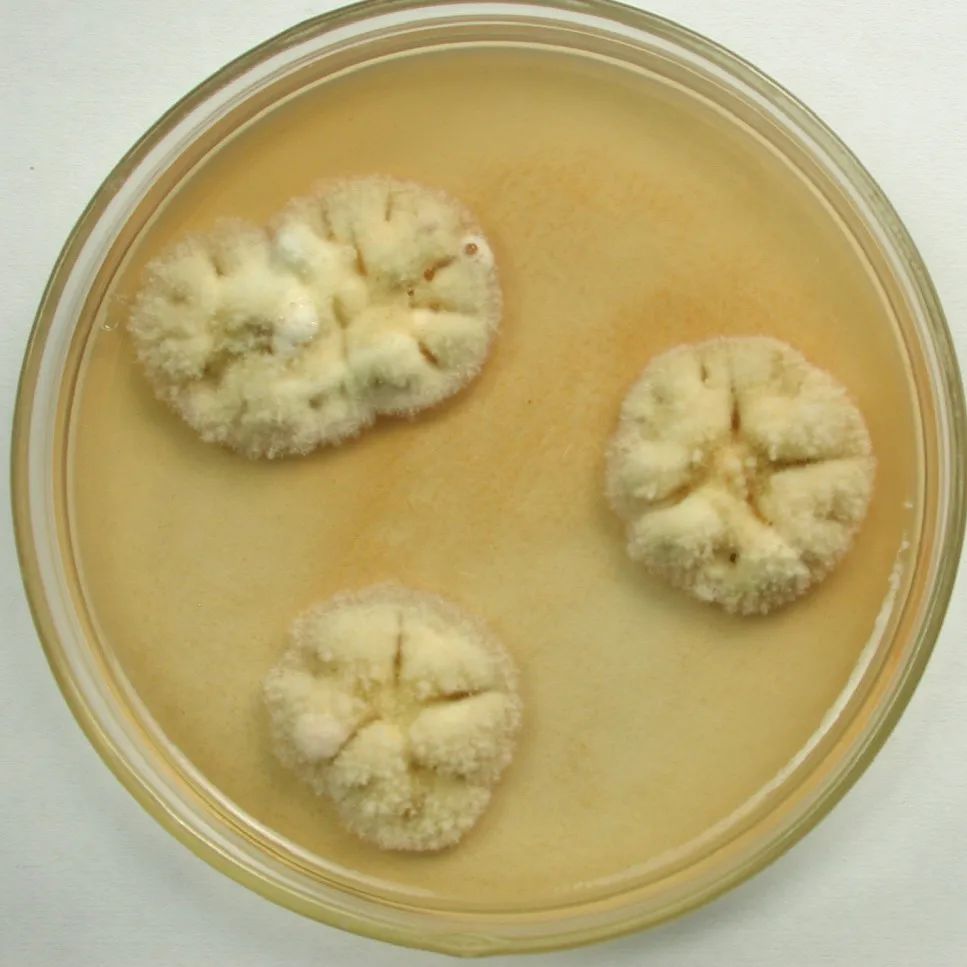
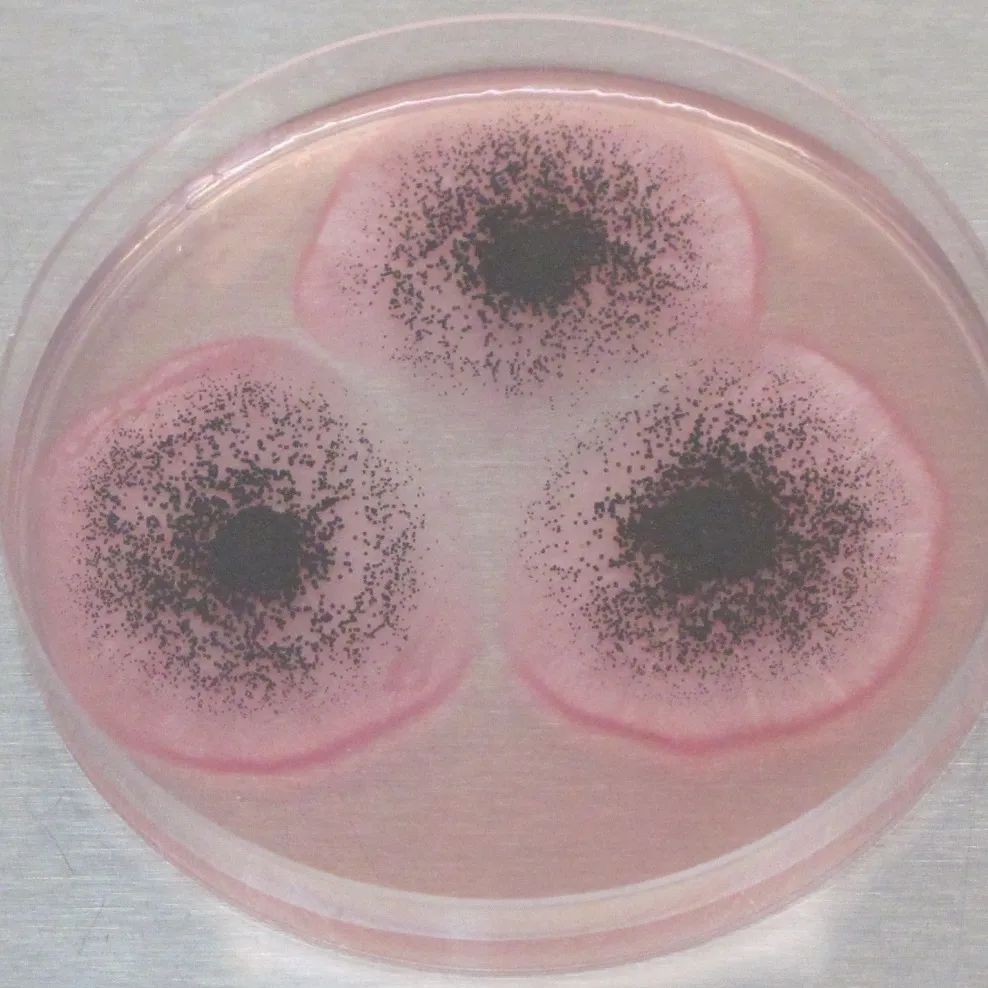
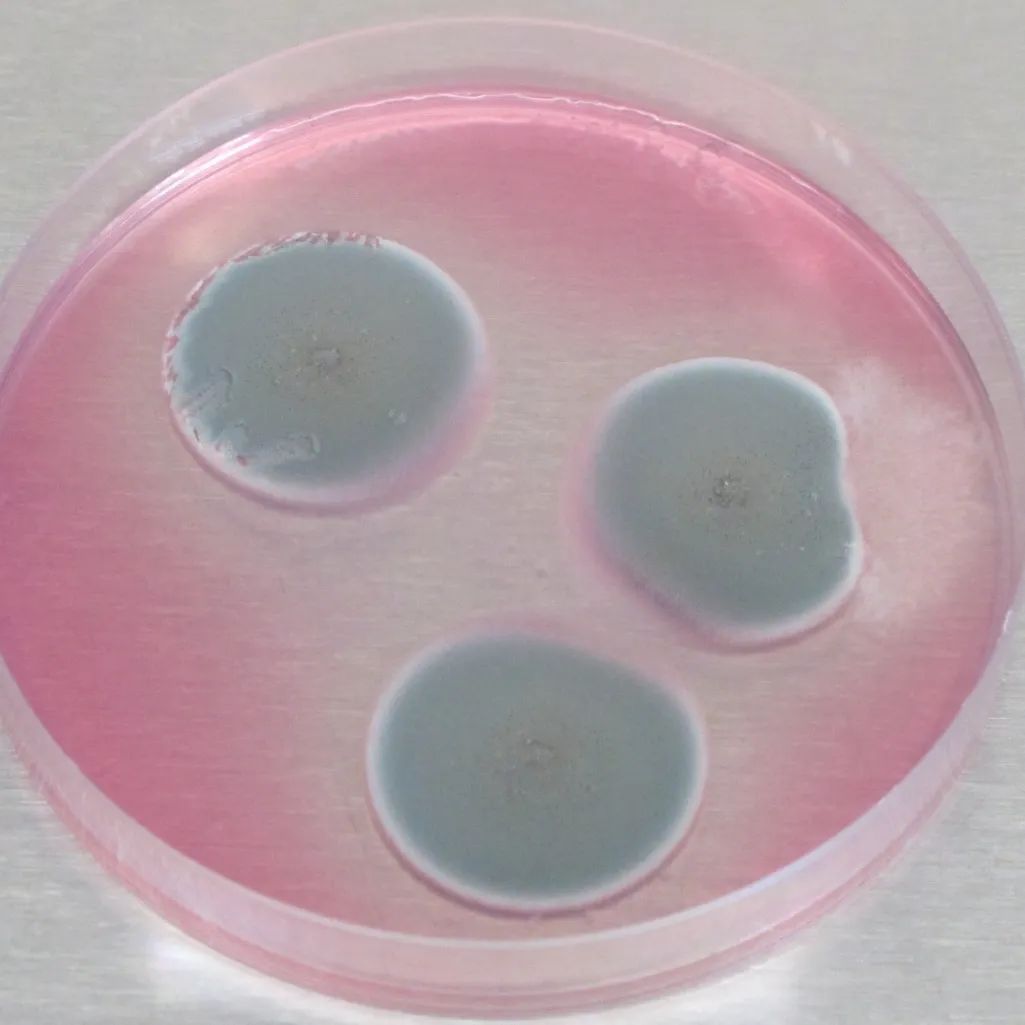
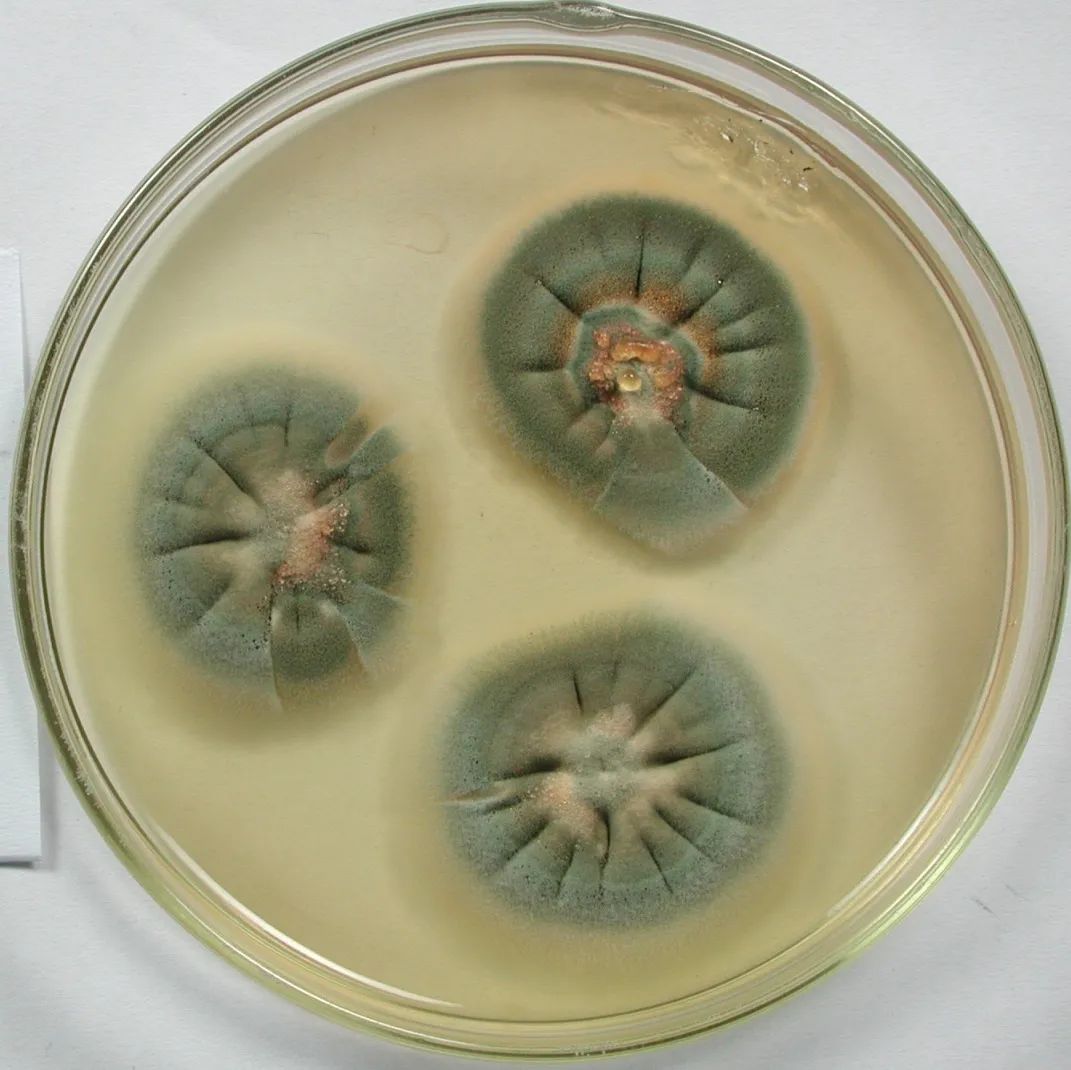

深度阅读
历经残破,重现精彩 | 防霉保护研究


防霉保护研究
秦俑二号坑等土遗址在室内发掘时,坑内空气不流通,湿度较大,出现了大量长霉的现象。为治理这一病害,1995年成立了秦俑遗址防霉害课题组,由此开启了秦陵博物院微生物防治工作的篇章。

兵马俑坑内曾出现的真菌以及地衣类微生物病害情况
在此之前,尽管开展了一些防霉工作,但未形成专业系统的研究工作方法,也未建立起专业实验室和专业人员团队。
防霉害课题组成立后,陆续承担了《秦俑土遗址及相关文物的防霉研究》等课题,对秦俑遗址及相关文物的霉害现状、霉害形成原因和菌种主要来源,进行了全面、细致的调查研究。



防霉保护研究工作
在秦俑坑遗址微生物(主要为霉菌)的活动情况调查中,共分离鉴定出48种霉菌种类,数理统计表明:青霉(Penicillum)、曲霉(Aspergillus)、根霉(Rhizopus)、木霉(Trichaderma)、头孢霉(Cephalosporium)占整个采样分离菌种的70%以上,无论从数量、或种类上,都是俑坑内的主要霉菌种群。
白曲霉点培养

白曲霉显微照片
黑曲霉点培养

黑曲霉显微照片
草酸青霉点培养

草酸青霉显微照片
桔青霉点培养

桔青霉显微照片
在微生物活动情况调查的基础上,开展防治技术研究,并以“中比第一期合作”为有力推手,与比利时杨森制药公司合作,搭建了国内文博系统首个科学化现代化的微生物防治实验室,在全国范围内展开了一系列的技术服务与研究工作。
通过课题研究,在解决秦俑土遗址及相关文物防霉保护的同时,建立了遗址区微环境监测系统,对温度、湿度、空气质量及微生物进行监测和定期巡查,为长期保护土遗址及文物不受霉害及其它损害奠定了基础。这种结合物理方法及俑坑环境改善等预防性保护措施的防霉方法,更具科学性、环保性和规范性,更能“对症下药”。

国家文物局科学和技术创新二等奖
2003年11月,《秦俑土遗址及相关文物防霉保护研究》项目通过国家文物局科技专家组结项验收,并于2005年11月获得国家文物局文物保护科学和技术创新奖二等奖。
秦俑遗址的防霉保护研究,为同类遗址性文物提供了参考和借鉴的经验,在对秦陵六号坑、秦陵青铜水禽坑和唐大明宫窑址等遗址的霉害治理中,取得了良好的应用效果。另外,还开展了古丝绸霉害调查及防治、壁画霉斑清洗等研究,并对秦陵周边和陕西省其它地区土遗址的霉害进行了治理与鉴定。

编 辑 | 大上造
校 稿 | 小 夏
审 核 | 周 萍